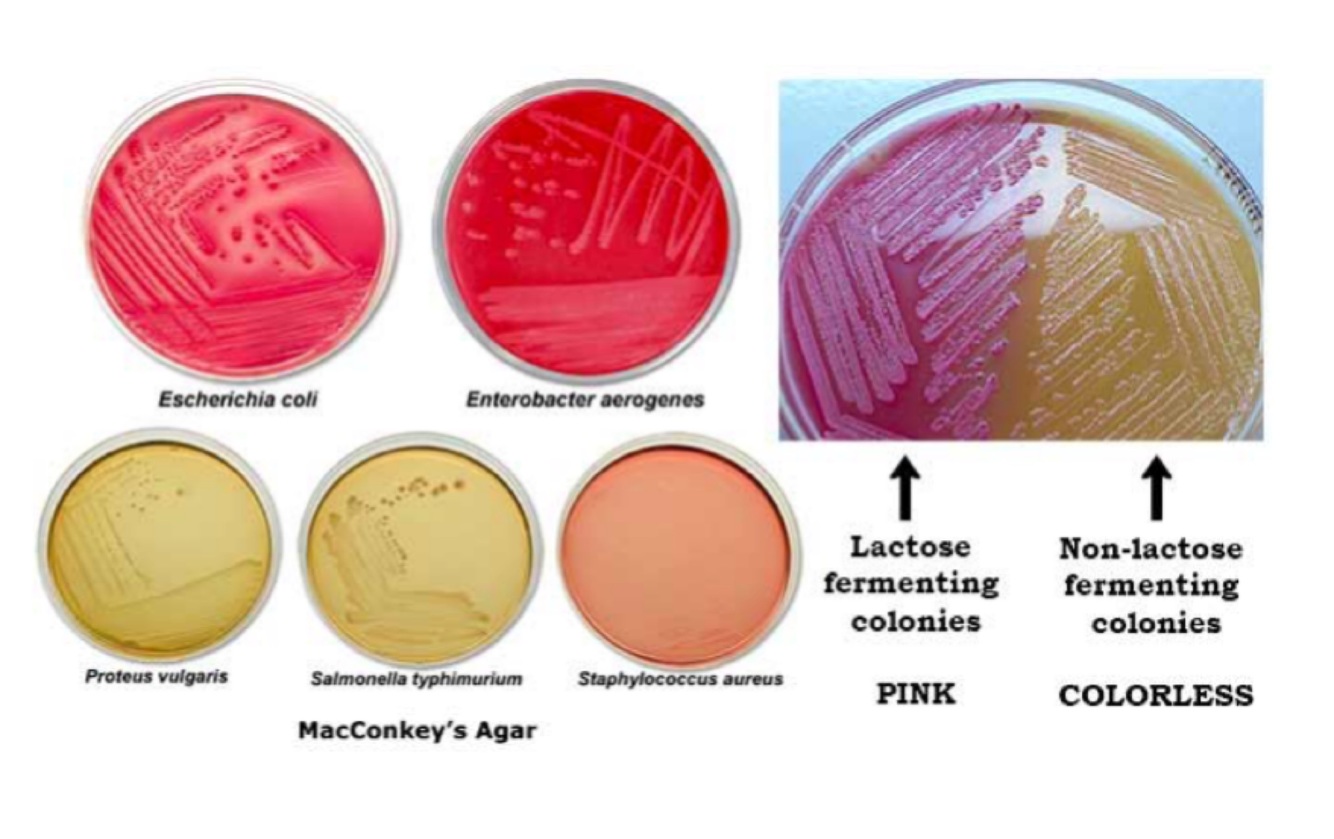

What does an application of safranin do in gram staining?
Stains gram negative bacteria PINK
gram positive remain PURPLE

Why does gram positive bacteria remain purple after decolorisation?
Thick layer of peptidoglycan in cell wall
Gram negative bacteria have a thin layer of peptidoglycan and a high lipid content
What are the four steps of gram staining?
Come In And Stain
Crystal violet (turns all cells purple)
Iodine
Alcohol (decolourisation)
Safranin (gram negative turn pink)
Which gram positive cocci produces an enzyme that converts fibrinogen to fibrin?
Staphylococcus aureus and MRSA: produce coagulase

Which test differentiates clusters vs chains in gram positive cocci?
Catalase test
Positive: Staphylococcus (clusters)
Negative: Streptococcus (chains)

Which groups does a haemolysis test differentiate streptococcus into?
Alpha: partial lysis (green)
Beta (Lancefield A, B,C + G): complete lysis (clear)
Gamma (Lancefield D): no lysis (non haem)

Which test can be used to differentiate alpha haemolytic streptococci?
Optochin test
Resistant: viridans strep
Sensitive: s. pneumoniae

Name two alpha haemolytic streptococci
Streptococcus pneumoniae
Viridans group streptococci

Which gram positive bacteria is beta haem group A?
Streptococcus pyogenes

Which gram positive bacteria are non-haem Group D?
Streptococcus bovis
Enterococcus
Infections associated with staphylococcus epidermidis
Surgical wound infections
Septicaemia
Endocarditis (prosthetic valve)
Infections associated with streptococcus pneumoniae
Pneumonia
Meningitis
Otitis media
Sinusitis
Treatment of MRSA infection
Vancomycin
Methicillin resistant s. aureus = MRSA
Test to initially differentiate gram negative bacilli
MacConkey Agar
Lactose fermenting: pink
Non lactose fermenting: white
Lactose fermenting gram negative bacilli
E. Coli
Klebsiella

Non lactose fermenting gram negative bacilli
Shigella
Salmonella
Pseudomonas

Oxidase positive non lactose fermenting gram negative bacilli
Pseudomonas
Produce cytochrome c oxidases

Oxidase negative non lactose fermenting gram negative bacilli
Shigella
Salmonella

Infections associated with E. Coli
UTIs (causes the majority)
Travellers diarrhoea
Cholecystitis
Cholangitis
Infections associated with pseudomonas and treatment
Skin infections
Pneumonia
Treatment: gentamicin, quinolones
Infections associated with shigella and treatment
Shigellosis (diarrhoea, fever)
Treatment: quinolones, azithromycin
Infections associated with neisseria and treatment
Gonorrhoea
Meningitis
Treatment: cephalosporins
Two examples of mycobacteria
TB
Leprosy
Stain used for mycobacteria
Ziehl-Nielsen stain
Acid fast bacteria: red
Non-acid fast: blue

















